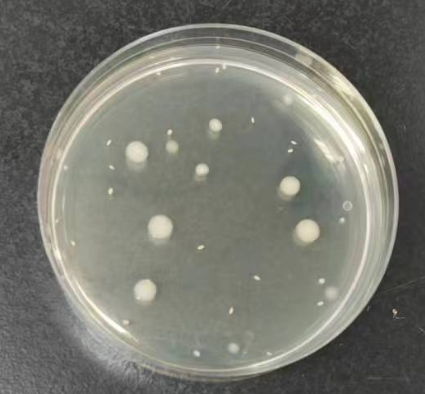

几种活菌计数法的比较和应用
发布时间:2023-11-01 浏览次数:11027
活菌计数法又称间接计数法。直接计数法测定到的是死、活细胞总数,间接计数法测得的仅是活菌数。这类方法所得的数值往往比直接计数法测得的数值小。活菌计数法一般有平板菌落计数法、MPN法、薄膜过滤计数法和比浊法。
1.平板菌落计数法:此法是基于每一个分散的活菌在适宜的培养基中具有生长繁殖并能形成一个菌落的能力。主要有倾注法、涂布法和螺旋接种法。
1.1 倾注法:先往培养皿中倾注一定量的菌液,然后再加入培养基,快速混匀,培养基凝固后,放入培养箱中培养。多用于菌落总数计数,操作简单。
优点:接种量可以是0.1-2mL之间,对微生物计数结果相对准确;操作简单,适用于各种样品中菌落总数的测定。
缺点:无法观察菌落特征,长在琼脂内部的细菌分离麻烦,不适于严格好氧菌和热敏感菌。样品量多时,接种前中后工作必须连续操作,很难简化。
1.2 涂布法:先将培养基熔化后趁热倒入无菌平板中,待凝固后吸取0.05-0.1mL菌悬液到琼脂平板上,再用无菌涂布棒将菌液在平板上涂抹均匀。将涂抹好的平板平放于桌上20 — 30min,使菌液渗透入培养基内,然后将平板倒转,保温培养,至长出菌落后即可计数。多用于菌落总数计数,操作简单。
优点:方便观察菌落形态。
缺点:接种量比较少,而且涂布棒会带走少量菌液,平行样间误差较大。要求样品悬液中没有大颗粒物(否则需要过滤),相对倾注法操作比较麻烦。
涂布计数法可以将倒平板和接种操作完全独立分开,适于流水化作业,适用面更广,促进了商品化成品平板的普及。

1.3 螺旋接种法:商业化的自动螺旋接种设备以阿基米德螺旋线的形式自动接种到琼脂平板表面,是涂布接种法的升级。多用于菌落总数计数,适用于接种工作量比较大的单位。
优点:方便观察菌落形态,均匀性较好,结果准确。
缺点:设备比较贵,启动和收尾工作相对麻烦。
2.MPN法:这是一种应用概率理论来估算细菌浓度的方法,多用于检测对检样含菌量不确定且精度要求不高样品。例如食品、水质中大肠菌群和食品中金黄色葡萄球菌检测。
3.薄膜过滤计数法:适用于检验含菌量低的液体或者气体样品。例如生活饮用水中总大肠菌的检验,医药用水和无菌制剂药品中微生物检测。

4.比浊法:适用于检验含菌量较高,对结果准确度要求不高、时效性要求比较高的样品。例如工业发酵中菌浓度监测,原料奶新鲜度的美兰实验,市场上也有很多自动比浊设备,如ATP荧光仪检测仪,微生物生长曲线检测仪……
